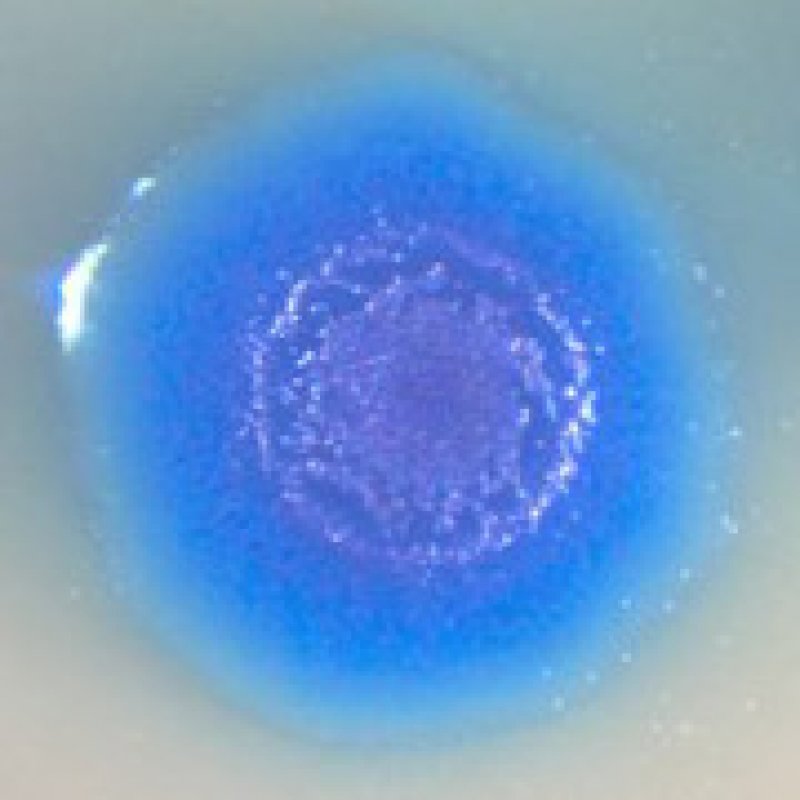

Синяя чума
Синяя чума 101 фото
Психоневрологический диспансер дневной стационар отзывы
Метр гонщик
Sintec 5w30 sp
Вебб котенок усатик или отважное сердце
Как мне тебе понравиться асадов
Травяной чай сбор трав
Игры губка боб 5
Статус картинка девочки
Микрофон fifine am8 белый
Платье для венчания 40
Список номеров телефонов мтс
Kick starter
Dark tower defense
Совместимость знаков зодиака мужчина скорпион женщина водолей
Логотип пабг мобайл
Использование личного автомобиля в командировке
Вылет 35 и 45 в чем разница
Шаровая опора рено логан оригинал
Извинить деревня
Gimoka кофе молотый